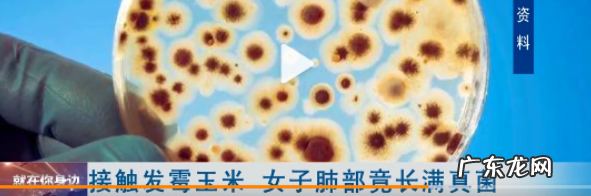

近日女子接触霉变玉米后肺部长满真菌时间在网络上迎来热议 , 于该女子肺部长满真菌的情况网友们十分关注 , 而肺部真菌感染一些网友也十分关心症状是怎么样的?接下来就让小编带大家详细了解吧!
文章插图
12月8日早间 , “女子接触霉变玉米后肺部长满真菌”冲上热搜第一 。
来自武汉务工的小刘一个多月咳喘不止 , 自行在家吃药也不见好转 , 于是她赶到医院 , 检查提示肺部有感染为了确定小刘感染的具体原因 , 医生紧急为她进行了肺泡灌洗 , 发现小刘肺部竟然长满黄曲霉菌 , 引发了真菌感染 , 这真菌怎么会长到肺里面呢? 经过详细询问病史 , 得知一个多月前 , 小刘曾回老家帮家人收玉米 。医生分析 , 她发病原因于此有关 。
医院呼吸与危重症医学科住院郭医师:“患者收的玉米可能已经被大量黄曲霉菌污染 , 在收玉米过程中 , 大量黄曲霉菌孢子扩散到空气中 , 而小刘没有采取任何防护措施 , 短时间内将大量黄曲霉菌吸入气道 , 在肺部定植 , 最终导致严重肺部感染 。”

文章插图
而肺部真菌感染在呼吸科比较常见 , 是由真菌感染引起的支气管-肺部疾病 , 包括原发性和继发性肺部真菌感染 。真菌孢子等被吸入人体肺部而致病称为原发性肺部真菌感染 。体内其他部位真菌感染经淋巴或血液到肺部而致病 , 称为继发性肺部真菌感染 。肺部真菌感染的危害是不容忽视的 , 那么肺部真菌感染的症状是什么呢?
1.隐匿性感染
多无明显的症状和体征 , 可自愈 。
2.流感样症状
多表现为发热、畏寒、头痛、流涕、关节痛、肌痛等 。3.肺部表现
(1)肺炎或支气管炎:最常见 , 与一般细菌性肺炎难以鉴别 。可有发热、咳嗽、咳白色黏稠痰或脓痰、咳血、胸闷、气喘等呼吸道症状 , 肺部可闻及干、湿性啰音 , 可伴有少至中量胸腔积液 。
(2)肺结核样表现:组织胞浆菌病、皮炎芽生菌病的临床表现有时酷似肺结核 , 可有干咳、咯血、胸痛等呼吸道症状及午后低热、盗汗等“结核中毒症状” 。
(3)肺脓肿和脓胸:常急性起病 , 可有寒战、高热(多呈弛张热)、咳嗽、咯黏液脓性痰 , 有时痰中臭味明显 , 咯血多为痰中带血 。
(4)肿瘤样表现:如肺隐球菌瘤、组织胞浆菌瘤、球孢子菌瘤等 , 酷似周围型肺癌 。皮炎芽生菌病、曲霉感染等可破坏肋骨与椎骨 , 似转移癌之骨质破坏 。
(5)肺栓塞和肺梗死:如嗜血管性的毛霉 , 易侵犯血管 , 诱发肺部感染时常导致肺栓塞甚至肺梗塞 , 症状类似肺血栓栓塞症 。
(6)其他:可引起弥漫性肺间质性病变 , 或类似结节病表现 。

文章插图
相关阅读:
福建一彭姓男子闻臭袜子的习惯已经有很久了 , 而这一次他因为咳嗽久治不愈 , 被诊断为肺部感染 , 医生说 , 这和他爱闻臭袜子有关系 。
这位男子 , 一开始只是有点咳嗽 , 但是想着是小事儿 , 就没有在意 , 一个星期之后并没有见好转 , 并且还胸闷了 , 于是就去医院检查 。检查的时候要医生看片子以一般的肺炎无异 , 就按着这个方式给他治疗 , 但是长时间后并没有效果 , 反而愈演愈烈 。于是二度去做检查 , 这一检查不要紧 , 肺炎成了肺部真菌感染 。
- 女子遛狗不牵绳还 女子遛狗不牵绳还骂人老不死被行拘
- 女子国家公祭日穿 女子国家公祭日穿和服上街被批评教育
- 女孩糖果卡喉邻桌 女孩糖果卡喉邻桌女子海姆立克救命
- 广州28岁女子恋 广州28岁女子恋爱1年被骗近千万
- 女子戴耳机听歌睡 女子戴耳机听歌睡觉致耳聋
- 交警1招解救2名 交警一招解救2名被拘禁女子
- 女子靠车窗睡着帽 女子靠车窗睡着帽子被冻玻璃
- 西安女子集中隔离 西安女子集中隔离哭着讨要卫生巾
- 女子回家路上被冷 女子回家路上被冷风吹成面瘫
- 女子每天1包坚果 女子每天1包坚果连吃3个月查出高血脂
特别声明:本站内容均来自网友提供或互联网,仅供参考,请勿用于商业和其他非法用途。如果侵犯了您的权益请与我们联系,我们将在24小时内删除。
